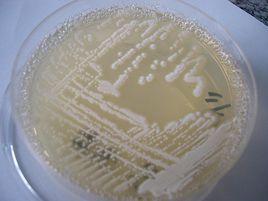
無花果絲孢酵母

脂肪酶的概述
近三十年來,脂肪酶的套用開發已從食品、助消化劑、化妝品、皮革加工、洗滌劑等領域擴伸到脂肪酸生產、油脂加工、有機合成化工產品、香料及藥物製備。八十年代以來,脂肪酶在套用方面的開發研究加快了步伐,除水解油脂已進人工業化外,利用脂肪酶不需要輔酶就能催化正逆反套用其專一性等優點,在有機溶劑中催化酶合成及酯交換反應、改性油脂的生產、消旋化合物拆分等眾多領域顯示出開發前景。
脂肪酶可分為動物脂肪酶、植物脂肪酶及微生物脂肪酶。微生物脂肪酶可用發酵法進行工廠化生產,生產周期短、規模大。
無花果絲孢酵母的分離
產脂肪酶菌株初篩方法:將待分離樣品稀釋法分離為純菌株,將各純菌株接種於含有溴甲酚紫的油脂同化平板上,30℃培養1小時。產脂肪酶的菌株能分解油脂生成脂肪酸,使溴甲酚紫由紫色變為黃色,形成變色圈。以菌落直徑與變色圈直徑之比為初篩依據。
產脂肪酶菌株復篩方法:將待測菌接於100mL發酵培養基中,30℃,搖床培養,定時測其脂肪酶活性。
脂肪酶活性測定方法:脂肪酶活性單位定義:37℃10分鐘油脂水解反應。將lml發酵液每分鐘分解底物產生lμmol脂肪酸定義為一個酶活單位 。
無花果絲孢酵母的鑑定
屬的鑑定
(1)液體培養特徵:麥芽汁培養基28℃靜置培養48小時,培養液較清,液面上形成一層酸膜,沒有氣泡不發酵。
(2)菌落形態:麥芽汁平板接種,28℃,7天,菌落白色,較大,表面乾燥,有放射狀菌絲線,邊緣呈細微毛邊。20℃,15天后菌落長滿平板。
(3)個體形態:馬鈴薯固體培養基畫線接種後,斜插入一蓋片,28℃培養5天,顯微鏡觀察蓋片上菌絲形態:有較長的真菌絲,菌絲有橫隔膜,在菌絲的末尾一端有許多橫隔膜,把菌絲切成條磚形,斷裂成單個細胞,排列成一左傾一右傾的細胞斷鏈,即形成節孢子。亦有芽殖,為多邊芽殖。無八疊式細胞群。
(4)孢子鑑定:不形成子囊飽子,不形成擲孢子,也不形成冬孢子及擔孢子,顯微鏡下觀察有大量節孢子,也有少量厚壁孢子。
由以上特徵,據《酵母菌分類學》,該菌為真菌門、半知菌亞綱、叢梗孢目、隱球酵母種,絲孢酵母屬(Trichosporon)。
種的鑑定
據王利1984年版《酶母菌分類學》,絲孢酵母屬共有15個種,按鑑定檢索表進行生理試驗,結果為:不同化硝酸鹽,不發酵葡萄糖,同化乳糖,無八疊狀細胞群,不同化肌醇,37℃能生長。據此判斷菌株為無花果絲孢酵母(Trichospfigucriac)。
無花果絲孢酵母產脂肪酶條件的研究
蛋白腖4%,橄欖油0.5%,KH2PO40.1%,MgSO40.1%,(NH4)2SO40.1%,pH5.0。在此基礎培養基中加入不同濃度的各種碳源,30'℃,搖瓶發酵48小時,測其酶活性。在0.5%的甜菜糖蜜為碳源時,酶活性最高,相對酶活(以葡萄糖碳源的酶活為100%)為407%。而葡萄糖碳源對產脂肪酶不利,可能是含葡萄糖培養基滅菌後生成了抑制酶形成的物質,或是葡萄糖效應抑制脂肪酶誘導生成的結果。底物類油脂可以作為碳源。
無花果絲孢酵母產脂肪酶性質的研究
將無花果絲孢酵母的30℃,48小時振盪培養物離心去菌體後,加入65%飽和度的硫酸鐵沉降酶蛋白,離心收集沉降物後,用透析膜透析硫酸鐵,再用聚乙二醇包埋法和低溫乾燥法製取酶粉。對該粗酶製劑進行酶性質的研究。
無花果絲孢酵母產脂肪酶的最適作用溫度
在25℃-52℃溫度範圍內測定了酶活性與溫度的關係,發現最適作用溫度為42℃。
無花果絲孢酵母產脂肪酶的最適作用pH
在pH5.0-10.0範圍內,測定了酶在不同pH緩衝體系下的活性,較適pH是7.0-9.0,pH8時酶活性最高。
無花果絲孢酵母產脂肪酶的熱穩定性
將酶分別在蒸餾水和pH6.5的Na2HPO4-檸檬酸緩衝液中於不同溫度下恆溫水浴處理15分鐘後,測定其殘餘酶活性,發現一定的溫度將使酶失活,而且酶在不同的體系中受熱,其耐熱性不同 。